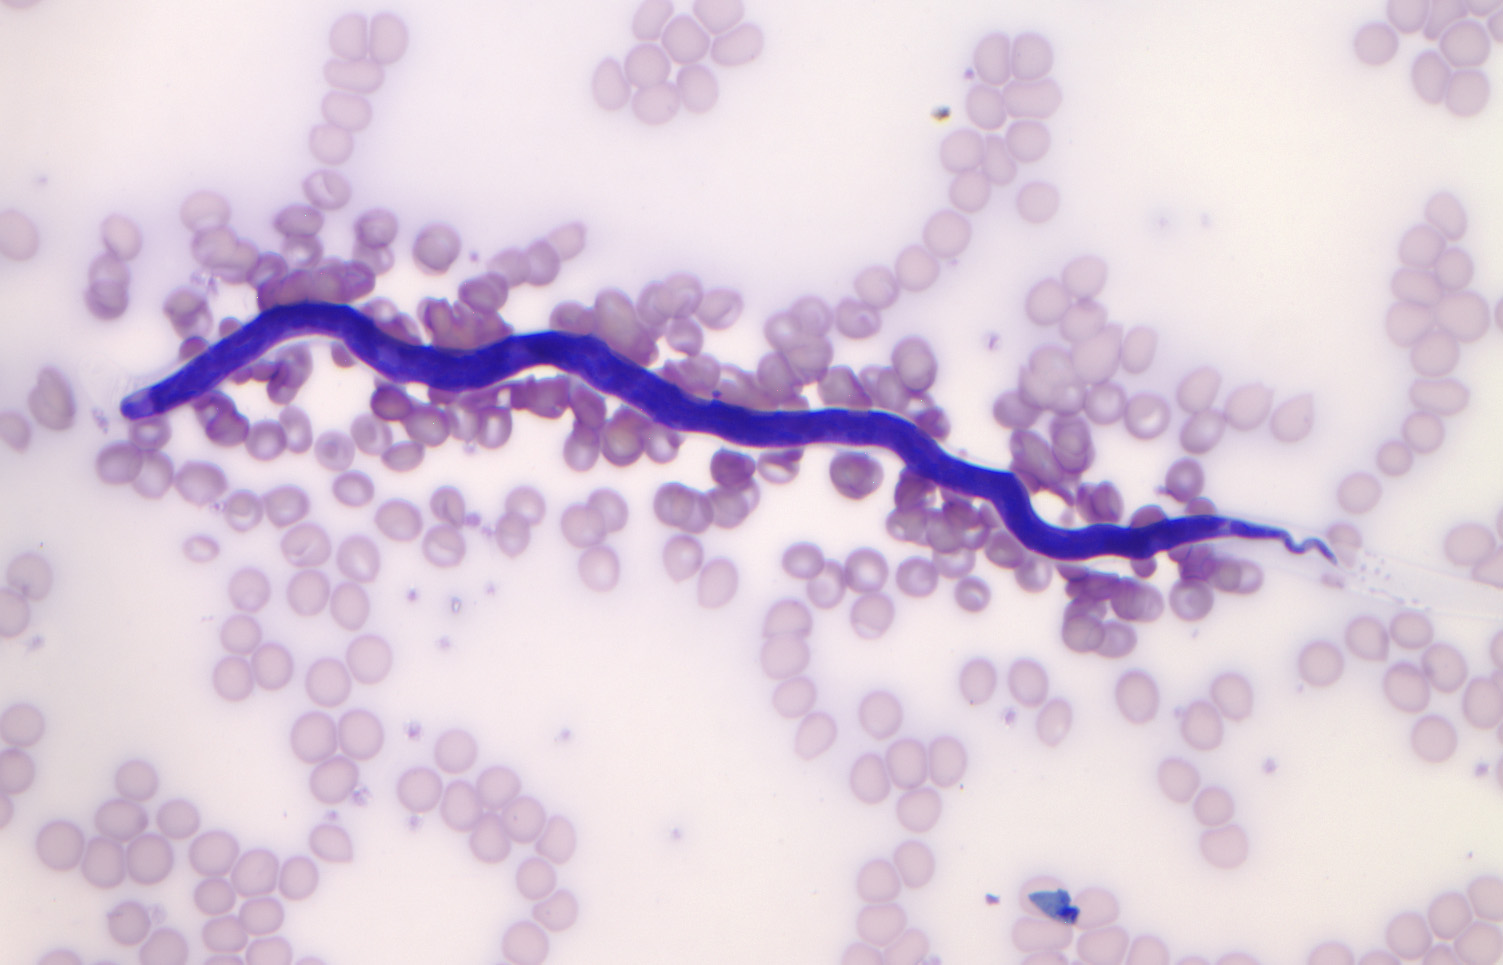

Как происходит заражение аскаридой: визуальное руководство

Раздел: Другие животные